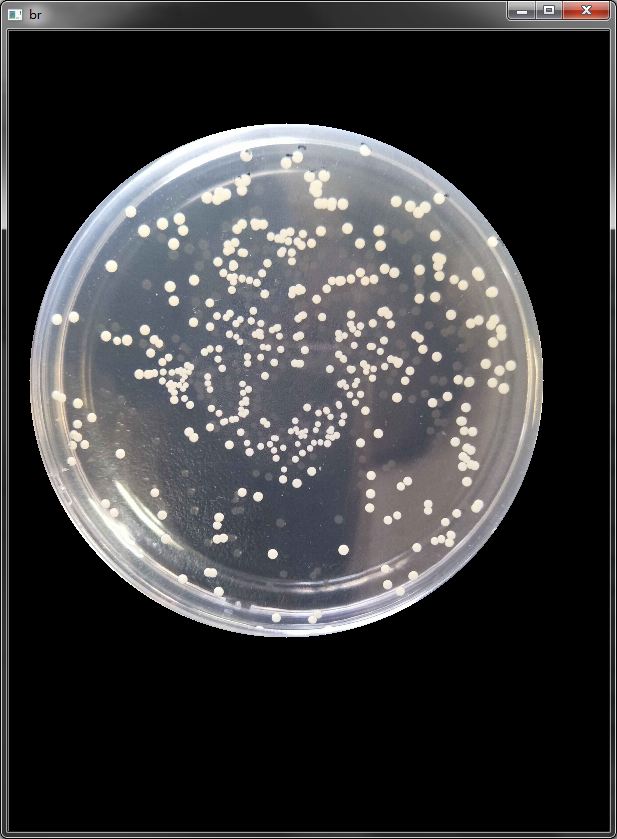
数量检测【hough,边缘分割,区域提取】_opencv 菌落计数-csdn博客
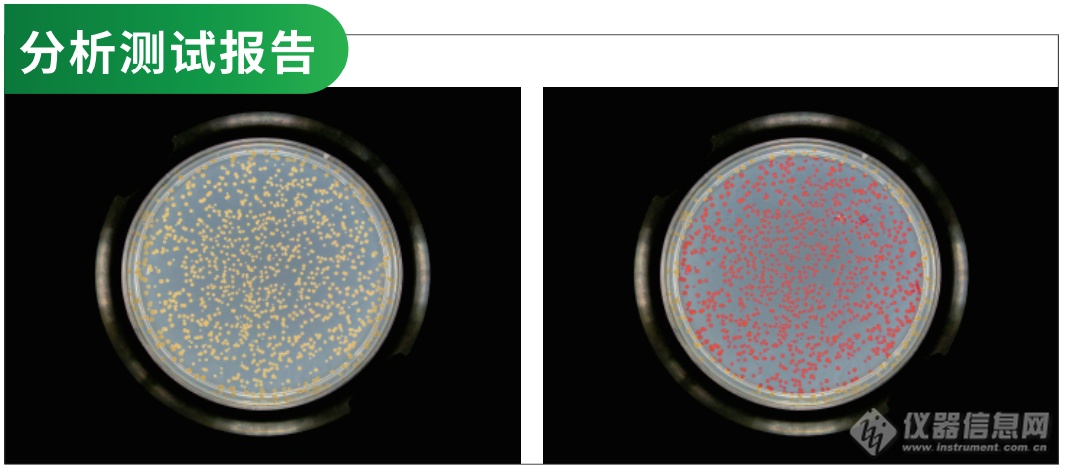
bc16全自动菌落计数仪 | 省时80%,计数1000个菌落仅需1秒!

菌落计数

图11-1 平板菌落计数法
图片尺寸471x391
手机菌落计数仪软件自动数菌落
图片尺寸4703x2939
防护用品的细菌菌落总数和真菌菌落总数检测方法采用平板计数法.
图片尺寸778x591
2.了解水源水的平板菌落计数的原则.
图片尺寸937x459
菌落计数
图片尺寸1080x1440
因为平板计数法的结果报告需要结合培养基菌落数和复发酵验证两方面
图片尺寸300x300
数量检测【hough,边缘分割,区域提取】_opencv 菌落计数-csdn博客
图片尺寸617x839
菌落计数器 菌落计数仪器 送2只计数笔 老款
图片尺寸800x800
scan-菌落计数仪
图片尺寸774x448
zx-300型全自动菌落计数仪
图片尺寸1000x548
bd800全自动影像分析菌落计数仪全自动菌落计数器细菌分析系统专业
图片尺寸1215x598
数智化升级|微生物检测掀起菌落计数新革命 - 自主发布 - 生物在线
图片尺寸2113x949
全自动菌落计数仪
图片尺寸500x500
zr1100系列全自动菌落计数仪
图片尺寸1280x847
菌落计数器 hicc-b 万深菌落计数仪
图片尺寸700x400
bc16全自动菌落计数仪 | 省时80%,计数1000个菌落仅需1秒!
图片尺寸1066x471
zx-200型 全自动菌落计数仪
图片尺寸1000x528
hicc-v型自动菌落计数,抑菌圈测定,细胞计数分析系统
图片尺寸1280x800
自动判读平板菌落计数器bd500
图片尺寸500x348
菌落总数计数
图片尺寸992x744